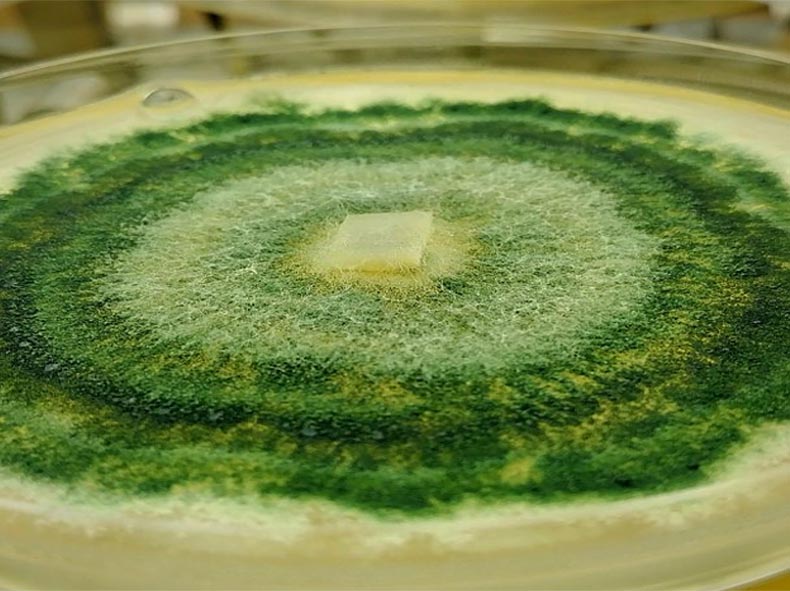
trihoderma-petrikutija

Cell Guard
Pokreće biljke bez kompromisa
Upoznajte Vašeg Novog Saveznika u Poljoprivredi
CELL GUARD
(Trihoderma harzianum)
Šta je Trihoderma?
Trihoderma vrste su korisne gljive prisutne u prirodnim zemljištima širom sveta, poznate po brzom rastu i sposobnosti da prežive nepovoljne uslove. Ove gljive se ističu svojim mehanizmima preživljavanja, uključujući formiranje zelenih konidija i plavih hlamidospora, koje im omogućavaju da opstanu čak i decenijama u ekstremnim uslovima, poput nedostatka hranljivih materija ili niskih temperatura.
Trihoderma harzianum je jedna od najmoćnijih predatorsko-parazitnih gljiva koja donosi brojne koristi vašoj proizvodnji, vrtu ili bašti. Kao odličan prerađivač organske materije u zemljištu i prirodni neprijatelj patogenih gljiva i bakterija, ona je ključna za očuvanje zdravlja biljaka i stimulaciju njihovog rasta.
Savremena poljoprivreda sve više prepoznaje značaj ove korisne gljive kao rešenja za mnoge izazove, uključujući suzbijanje bolesti, povećanje prinosa i očuvanje životne sredine.
Zašto odabrati preparat CELL GUARD na bazi gljive Trihoderma harzianum?
CELL GUARD preparat sadrži visoku koncentraciju enkapsulirane gljive Trihoderma harzianum, koja je prirodni stimulator rasta ali i saveznik biljaka u borbi protiv fitopatogenih mikroorganizama. Primenom napredne tehnologije mikroenkapsuliranja značajno je povećana otpornost gljive na spoljne uslove, kao i lakoća primanja preparata u zemljištu a posebno u zoni korena. Kolonizacijom korena, Trihoderma formira zaštitnu mrežu hifa koja sprečava lak prodor patogena, smanjuje mogućnost infekcije i vrši prirodnu dezinfekciju zemljišta, čime omogućava uspešno gajenje biljaka čak i u monokulturi.
Trihoderma harzianum deluje na širok spektar patogena, uključujući:
Gljivice: Fusarium, Rhizoctonia, Phytophthora, Botrytis, Alternaria, Pythium, Colletotrichum, Verticillium, Sclerotinia, Monilinia, Venturia, Cercospora, i Armillaria.
Bakterije: Agrobacterium, Xanthomonas, Pseudomonas, Erwinia i mnoge druge.
Primena CELL GUARD preparata ne samo što deluje na patogene već i značajno doprinosi revitalizaciji biljaka i očuvanju ekološkog balansa.
Ekološki Prihvatljivo
CELL GUARD je organski mikrobiološki preparat koji doprinosi održavanju ekološke ravnoteže jer smanjuje upotrebu pesticida i đubriva. To ga čini savršenim za primenu u organskoj, integralnoj i ZERO RESIDUE poljoprivrednoj proizvodnji, gde je od neprocenjive važnosti sačuvati pčele i druge korisne insekte.
Cell Guard
Aktivator imuniteta biljaka
CELL GUARD aktivira indukovani sistemski imunitet (Induced Systemic Resistance – ISR) kod biljaka. Ovo je oblik prirodnog imuniteta koji biljka koristi za odbranu od širokog spektra patogena i stresnih faktora.
Mehanizam aktivacije ISR-a:
Kolonizacija korena: Trihoderma harzianum kolonizuje površinu korena biljke i uspostavlja blisku interakciju sa biljnim tkivima.
Signalni molekuli: Gljiva stimuliše biljku da proizvodi signalne molekule poput Jasmonske kiseline (JA) koja je uključena u otpornost na patogene i insekte i Etilena (ET) koji pomaže u signalizaciji i odgovoru na stres.
Sistemska otpornost: Aktivacija ISR-a dovodi do povećane spremnosti biljke da reaguje na napad patogena kroz: Proizvodnju antimikrobnih jedinjenja, Ojačavanje ćelijskih zidova i Regulaciju gena povezanih sa odbranom.
- Prednosti ISR-a aktiviranog Trihodermom:
Šira zaštita: Ovaj tip imuniteta omogućava biljci da se efikasno brani od raznih patogena (gljivica, bakterija, pa čak i nekih insekata). - Energetska efikasnost: Za razliku od drugih oblika odbrane, ISR ne opterećuje biljku dok patogen nije prisutan.
Kao rezultat, biljke tretirane gljivom Trihoderma harzianum postaju otpornije na bolesti i abiotski stres, što doprinosi zdravijem rastu i većim prinosima.
Trihoderma harzianum primarno aktivira Indukovani sistemski imunitet (Induced Systemic Resistance – ISR), ali u nekim slučajevima može delimično doprineti aktivaciji Sistemski stečenog imuniteta (Systemic Acquired Resistance – SAR).
Iako Trihoderma harzianum primarno ne aktivira SAR, njena interakcija sa biljkom može indirektno pokrenuti proizvodnju signalnih molekula, uključujući salicilnu kiselinu, u manjoj meri. To se posebno dešava kada biljka detektuje patogen u prisustvu Trihoderme, što može dovesti do:
Jače sistemske otpornosti putem kombinacije ISR i SAR.
Bržeg i jačeg odgovora biljke na buduće infekcije.
Ojačavanje ćelijskih zidova:
CELL GUARD indukuje taloženje lignina i drugih jedinjenja koja ojačavaju ćelijske zidove u tkivima biljaka i tako dodatno otežavaju patogenima prodiranje u biljno tkivo. Ovakva dinamična reakcija pruža biljkama sposobnost da izgrade efikasnu unutrašnju odbranu protiv budućih napada različitih patogena, čak i onih koji bi inače prouzrokovali ozbiljne gubitke prinosa.
Cell Guard – delovanje preparata na biljke u uslovima suše
Stres usled suše i mraza:
Poboljšana apsorpcija vode: CELL GUARD poboljšava razvoj korena gde dolazi do povećanja njegove zapremine i do 10 puta. Time se poboljšava efikasnost apsorpcije vode i pomaže biljci da pristupi vodi iz dubljih slojeva zemljišta i time umanji efekat suše.
Osmotsko prilagođavanje: Tretirane biljke pokazuju poboljšano osmotsko prilagođavanje, što pomaže održavanju turgora ćelija i smanjenju gubitka vode iz biljnih ćelija u uslovima nedostatka vode, odnosno suše.
Regulacija Hormona Stresa: CELL GUARD stimuliše proizvodnju hormona povezanih sa stresom, kao što je apcinska kiselina (ABA). ABA pomaže u regulaciji potrošnje vode zatvaranjem stoma kako bi se smanjio gubitak vode putem transpiracije. Ovaj hormon takođe pokreće mehanizme koji pomažu biljkama da čuvaju vodu tokom suše.
Povećana sinteza hormona za stimulaciju rasta biljaka: CELL GUARD proizvodi supstance koje podstiču rast i razvoj biljaka, poput auksina i citokinina, što pomaže biljkama da održe rast čak i pod stresom od suše.
Cell Guard – delovanje preparata na biljke u uslovima mraza
Trihoderma harzianum pomaže biljkama da se nose sa stresom izazvanim niskim temperaturama i mrazom kroz niz biohemijskih, fizioloških i mikrobioloških mehanizama, što je potvrđeno u različitim naučnim studijama. Ovi mehanizmi uključuju:
1. Indukcija sistemskog imuniteta (ISR): Trihoderma harzianum aktivira signalne puteve u biljci povezane sa hormonima poput jasmonske i salicilne kiseline. Ovi signalni putevi pripremaju biljku za efikasniju reakciju na abiotski stres, uključujući hladnoću i mraz. Ova priprema smanjuje oštećenje ćelijskih membrana koje nastaje usled stvaranja leda unutar ili oko biljnih ćelija.
2. Proizvodnja antifriz proteina: Prisustvo Trihoderme može stimulisati biljke da sintetišu proteine koji deluju kao prirodni antifriz. Ovi proteini ometaju stvaranje i širenje kristala leda, čime se smanjuje šteta izazvana mrazom.
3. Sinteza osmoprotektanata: Trihoderma pomaže biljkama da povećaju proizvodnju osmoprotektanata, poput prolina, betaina i šećera, koji stabilizuju ćelijske membrane i proteine tokom perioda niskih temperatura. Osmoprotektanti takođe smanjuju gubitak vode iz ćelija, čime dodatno štite biljku.
4. Poboljšanje korenovog sistema i apsorpcije vode: Kolonizacija korena Trihodermom jača korenov sistem, poboljšavajući njegovu sposobnost apsorpcije vode čak i u nepovoljnim uslovima izazvanim mrazom. Ovo smanjuje rizik od dehidracije biljaka koja je čest problem tokom perioda mraza.
5. Regulacija antioksidativnog sistema biljke: Trihoderma harzianum povećava aktivnost antioksidativnih enzima u biljkama, kao što su katalaza, peroksidaza i superoksid dismutaza. Ovi enzimi neutralizuju reaktivne forme kiseonika koje se povećavaju tokom mraza i smanjuju oksidativni stres u biljci.
6. Poboljšanje mikroklimatskih uslova u rizosferi: Trihoderma proizvodi metabolite koji mogu uticati na mikroklimatske uslove u rizosferi, kao što su povećanje dostupnosti hranljivih materija i stvaranje toplotne stabilnosti u zoni korena. Ovo pomaže biljci da bolje izdrži stres izazvan hladnim okruženjem.
7. Regulacija hormona rasta: Trihoderma utiče na balans hormona kao što su giberelini i citokinini, koji podržavaju normalan rast biljke čak i pod stresnim uslovima. Smanjuje se efekat stresa izazvanog etilenom, koji može dodatno pogoršati oštećenje izazvano mrazom.
Trihoderma harzianum povećava toleranciju biljaka na mraz kombinacijom bioloških i biohemijskih mehanizama, uključujući jačanje korena, povećanje otpornosti ćelija na hladnoću i aktiviranje biljnih odbrambenih sistema. Ova gljiva pruža značajnu podršku u održivoj poljoprivredi, smanjujući zavisnost od hemijskih tretmana i povećavajući sposobnost biljaka da izdrže niske temperature.
Cell Guard – delovanje preparata na biljke u uslovima obimnih padavina i zabarenosti
Trihoderma harzianum značajno pomaže biljkama da se nose sa stresom izazvanim nedostatkom kiseonika (hipoksijom), posebno u uslovima prekomerne vlažnosti ili zabarivanja zemljišta. Ona proizvodi bioaktivne jedinjenja, poput siderofora i enzima, koja pomažu biljci u efikasnijem iskorišćavanju dostupnih resursa, čime se smanjuje stres izazvan nedostatkom kiseonika.
Izuzetni rezultati delovanja preparata Cell Guard postižu se u hidroponskim uslovima gajenja, gde je koren biljaka potopljen u tečni hranljivi rastvor. Prisustvo Trihoderma harzianum u ovom sistemu značajno smanjuje nivo stresa, posebno onog izazvanog nedostatkom kiseonika i prisustvom potencijalno toksičnih supstanci. Na taj način, biljke mogu nesmetano nastaviti sa rastom i razvojem, uz poboljšanu apsorpciju hranljivih materija i povećanu otpornost na nepovoljne uslove.
U anaerobnim uslovima, Trihoderma razgrađuje organske materije i smanjuje akumulaciju toksičnih supstanci poput amonijaka i sulfida, čime smanjuje njihovu koncentraciju u zemljištu.
Poboljšava mikrobiološku ravnotežu u rizosferi, povećavajući prisustvo korisnih mikroorganizama koji podržavaju zdravlje biljaka čak i u nepovoljnim uslovima.
Aktiviranjem Indukovane sistemske otpornosti (ISR), Trihoderma povećava sposobnost biljke da se prilagodi hipoksičnim uslovima, podstičući biljku da proizvodi antioksidanse i druge molekule koji štite ćelije od oštećenja izazvanih stresom.
Trihoderma utiče na proizvodnju hormona poput etilena, čija prekomerna količina može štetno uticati na biljke u uslovima hipoksije, regulišući hormonski balans i smanjujući štetu izazvanu stresom.
Visoka vlažnost često stvara povoljne uslove za razvoj gljivičnih i bakterijskih bolesti, ali Trihoderma doprinosi očuvanju biljaka na razne načine:
1. Suzbijanje patogena koji se razvijaju u vlažnim uslovima
* Mikoparazitizam: Trihoderma napada i razgrađuje ćelijske zidove patogenih gljiva, kao što su Fusarium, Pythium, i Phytophthora, koje se razvijaju u uslovima visoke vlažnosti.
* Produkcija antimikrobnih jedinjenja: Proizvodi metabolite koji inhibiraju rast patogena, smanjujući rizik od infekcija.
2. Poboljšanje zdravlja korenovog sistema
U uslovima prekomerne vlage, koren može patiti od slabog snabdevanja kiseonikom. Trihoderma poboljšava zdravlje korena kroz povećanje dostupnosti hranljivih materija (npr. fosfora i gvožđa), čime jača biljku.
Cell Guard – delovanje preparata na biljke u uslovima visoke EC vrednosti
Homeostaza jona: CELL GUARD poboljšava sposobnost biljke da održava homeostazu jona tako što smanjuje unos toksičnih jona poput natrijuma (Na+) i poboljšava unos esencijalnih hranljivih materija. Nakon primene preparata dolazi do optimizacija EC u zoni korena biljke, čime se biljka oslobađa nastalog pritiska soli.
Osmotsko prilagođavanje: Jedan od ključnih načina na koji Cell Guard deluje je poboljšanje osmotskog, turgorovog i zidnog pritiska unutar biljaka prilikom povećnog saliniteta, ili usled nedostatka vode. Ove promene na ćelijskom nivou doprinose poboljšanom usvajanju mineralnih đubriva, dok se istovremeno smanjuje štetni uticaj soli na biljku. Ovo praktično znači da biljka može da usvoji veću količinu đubriva bez posledica blokade korena, što rezultuje povećanjem prinosa i produktivnosti.
Indukovanje signalnih puteva stresa: CELL GUARD pokreće određene signalne puteve povezane sa stresom čak i kada biljke nisu u stresnim uslovima. Ovaj “preventivni” efekat priprema biljku da reaguje efikasnije kada dođe do stvarnog stresa.
Poboljšanje ukupnog zdravlja biljke: Tretmani preparatom često dovode do boljeg rasta biljaka, apsorpcije hranljivih materija i ukupnog zdravlja. Zdrave biljke su daleko otpornije na abiotski stres. Pored toga Trihoderma harzianum proizvodi širok spektar isparljivih organskih jedinjenja (VOC) koja pomažu u aktivaciji imuniteta, stimulaciji rasta i pravilnog razvoja biljaka. Ova jedinjenja su pokazala da mogu promovisati rast korena, poboljšati otpornost biljaka na stres i pomoći u suzbijanju različitih patogena.
Kombinacijom poboljšanja otpornosti biljaka na bolesti, poboljšanja usvajanja đubriva i smanjenja štetnih uticaja soli, preparat CELL GUARD na bazi gljive Trihoderma harzianum predstavlja sveobuhvatno rešenje za poljoprivrednike.
Perspektive za budućnost
Kombinacija sa drugim mikroorganizmima: Udruženi efekti sa našim drugim preparatima zasnovanih na SMART TEHNOLOGIJI značajno poboljšavaju efikasnost prirodne zaštite, stimulacije razvoja biljaka i njihove otpornosti na stres
Unapređenje proizvodnih tehnologija: Produženje izdržljivosti preparata tokom perioda skladištenja, kao i nakon primene enormno je povećano u poređenju sa konkurentskim proizvodima primenom najnovije tehnologije mikroenkapsulacije.